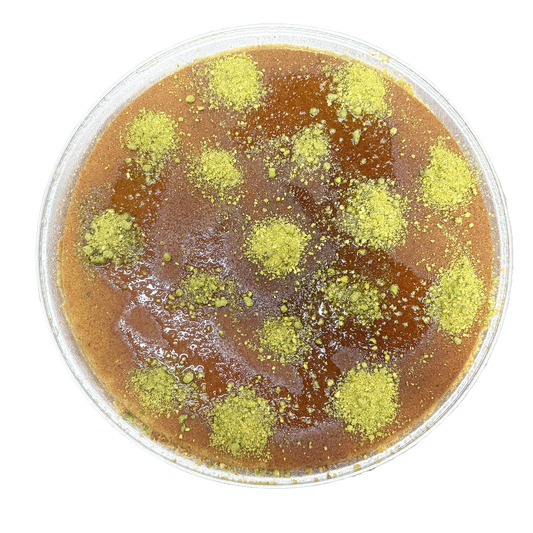
Large Knafeh Naameh Tray 18 Inch

Collection: Order Online
NATIONWIDE SHIPPING: ORDERS PLACED BY 2:00PM SHIP SAME DAY!
PICK UP SERVICE HOURS: TUE-SUN 10:30AM-9:00PM (Closed Monday)
-
Anise Cookies 1 lb
Vendor:Victory SweetsRegular price $13.95 USDRegular priceUnit price / per -
 Sold out
Sold outAttayif 1 lb
Vendor:Victory SweetsRegular price $13.95 USDRegular priceUnit price / per -
Basbousa Tray
Vendor:Victory SweetsRegular price $109.95 USDRegular priceUnit price / per -
Bird's Nest Baklava 1 lb
Vendor:Victory SweetsRegular price $21.95 USDRegular priceUnit price / per -
Cashew Baklava 1 lb
Vendor:Victory SweetsRegular price $17.95 USDRegular priceUnit price / per -
 Sold out
Sold outChocolate Pistachio Baklava
Vendor:Victory SweetsRegular price From $1.95 USDRegular priceUnit price / per -
Date Mammoul Cookies 1 lb
Vendor:Victory SweetsRegular price $13.95 USDRegular priceUnit price / per -
Holiday Baklava Gift Box 18 Count 1 lb
Vendor:Victory SweetsRegular price $17.95 USDRegular priceUnit price / per -
Knafeh Sesame Kaak Sandwich
Vendor:Victory SweetsRegular price From $8.95 USDRegular priceUnit price / per -
Kunafa Rolls 1 lb
Vendor:Victory SweetsRegular price $15.95 USDRegular priceUnit price / per -
Kunafa Rolls Tray
Vendor:Victory SweetsRegular price From $54.95 USDRegular priceUnit price / per -
Large Assorted Baklava Gift Box 50 Count 3 lbs
Vendor:Victory SweetsRegular price $59.95 USDRegular priceUnit price / per -
Large Knafeh Khishneh Tray 18 Inch
Vendor:Victory SweetsRegular price $84.95 USDRegular priceUnit price / per -
Large Knafeh Naameh Tray 18 Inch
Vendor:Victory SweetsRegular price $84.95 USDRegular priceUnit price / per -
Medium Assorted Baklava Tray 36 Count 2 lbs
Vendor:Victory SweetsRegular price $44.95 USDRegular priceUnit price / per -
Medium Knafeh Khishneh Tray 16 Inch
Vendor:Victory SweetsRegular price $74.95 USDRegular priceUnit price / per -
Medium Knafeh Naameh Tray 16 Inch
Vendor:Victory SweetsRegular price $74.95 USDRegular priceUnit price / per -
Petit Four Butter Cookies Medium Tray 36 count 2 lbs
Vendor:Victory SweetsRegular price $34.95 USDRegular priceUnit price / per -
Pistachio Baklava
Vendor:Victory SweetsRegular price From $1.95 USDRegular priceUnit price / per -
Pistachio Burma 1 lb
Vendor:Victory SweetsRegular price $25.00 USDRegular priceUnit price / per -
Pistachio Date Maamoul Cookies 1 lb
Vendor:Victory SweetsRegular price $15.95 USDRegular priceUnit price / per -
Pistachio Harisa 1 lb
Vendor:Victory SweetsRegular price $13.95 USDRegular priceUnit price / per -
Pistachio Mammoul Cookies 1 lb
Vendor:Victory SweetsRegular price $15.95 USDRegular priceUnit price / per -
Sesame Date Maamoul Cookies 1 lb
Vendor:Victory SweetsRegular price $13.95 USDRegular priceUnit price / per -
Small Assorted Baklava Tray 18 Count 1 lb
Vendor:Victory SweetsRegular price $17.95 USDRegular priceUnit price / per -
Small Knafeh Khishneh Tray 12 Inch
Vendor:Victory SweetsRegular price $44.95 USDRegular priceUnit price / per -
Small Knafeh Naameh Tray 12 Inch
Vendor:Victory SweetsRegular price $44.95 USDRegular priceUnit price / per -
Walnut Mammoul Cookies 1 lb
Vendor:Victory SweetsRegular price $13.95 USDRegular priceUnit price / per

Made Fresh Daily
From our inception, we've taken pride in using time-honored techniques and the highest quality ingredients to create an array of delectable pastries, and sweets.